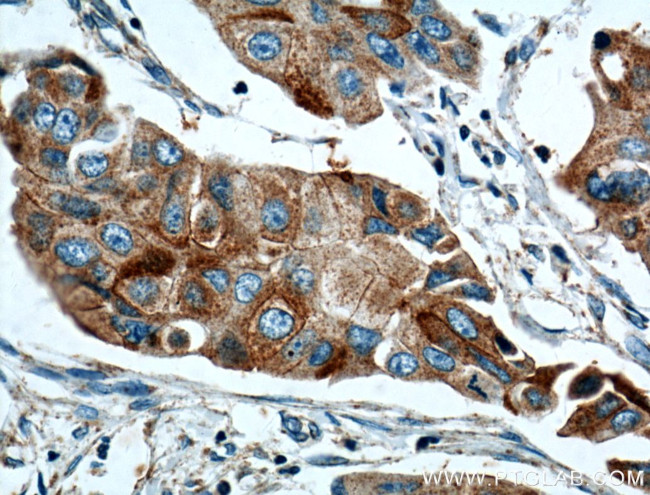
ANXA9 Antibody in Immunohistochemistry (Paraffin) (IHC (P))
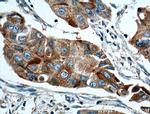
ANXA9 Antibody in Immunohistochemistry (Paraffin) (IHC (P))

Search
Proteintech
ANXA9 Polyclonal Antibody
{{$productOrderCtrl.translations['antibody.pdp.commerceCard.promotion.promotions']}}
{{$productOrderCtrl.translations['antibody.pdp.commerceCard.promotion.viewpromo']}}
{{$productOrderCtrl.translations['antibody.pdp.commerceCard.promotion.promocode']}}: {{promo.promoCode}} {{promo.promoTitle}} {{promo.promoDescription}}. {{$productOrderCtrl.translations['antibody.pdp.commerceCard.promotion.learnmore']}}
产品信息
15416-1-AP
种属反应
宿主/亚型
分类
类型
抗原
偶联物
形式
浓度
规格
纯化类型
保存液
内含物
保存条件
运输条件
产品详细信息
Immunogen sequence: STMSVTGGK MAPSLTQEIL SHLGLASKTA AWGTLGTLRT FLNFSVDKDA QRLLRAITGQ GVDRSAIVDV LTNRSREQRQ LISRNFQERT QQDLMKSLQA ALSGNLERIV MALLQPTAQF DAQELRTALK ASDSAVDVAI EILATRTPPQ LQECLAVYKH NFQVEAVDDI TSETSGILQD LLLALAKGGR DSYSGIIDYN LAEQDVQALQ RAEGPSREET WVPVFTQRNP EHLIRVFDQY QRSTGQELEE AVQNRFHGDA QVALLGLASV IKNTPLYFAD KLHQALQETE PNYQVLIRIL ISRCETDLLS IRAEFRKKFG KSLYSSLQDA VKGDCQSALL ALCRAEDM (1-345 aa encoded by BC005830)
靶标信息
The annexins include ANXA9 coded protein, which are a family of calcium-dependent phospholipid-binding proteins. Members of the annexin family contain 4 internal repeat domains, each of which includes a type II calcium-binding site. The calcium-binding sites are required for annexins to aggregate and cooperatively bind anionic phospholipids and extracellular matrix proteins. Annexin A9 is a divergent member of the annexin protein family in which all four homologous type II calcium-binding sites in the conserved tetrad core contain amino acid substitutions that ablate their function. However, structural analysis suggests that the conserved putative ion channel formed by the tetrad core is intact.
仅用于科研。不用于诊断过程。未经明确授权不得转售。
篇参考文献 (0)
生物信息学
蛋白别名: annexin 31; Annexin A9; Annexin XXXI; Annexin-31; Annexin-9; ANXA9; Pemphaxin
基因别名: 1110003P15Rik; 2310069F17Rik; ANX31; ANXA9
UniProt ID: (Human) O76027, (Mouse) Q9JHQ0
Entrez Gene ID: (Human) 8416, (Mouse) 71790